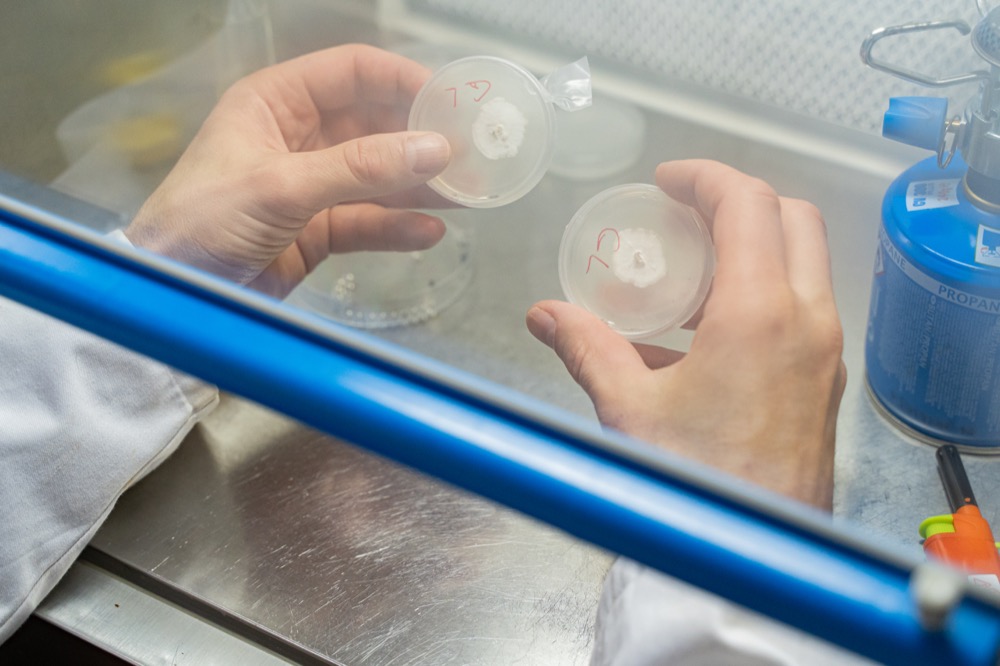

Alt lab is a non-disciplinary research laboratory dedicated to artistic-scientific research and implementation of interdisciplinary projects.
Alt lab fills the gap between the raised awareness of environmental changes and the Anthropocene, artistic practices, scientific experiments, and daily habits around our kitchens. People in the lab share their knowledge, de-mystify scientific experiments, and sophisticated artistic mythos.
We invite artists and researchers to join the lab. We seek those who are engaged in non-disciplinary activities that require access to laboratory equipment and artistic, scientific, and technological knowledge.
Facilities
A cozy, bright and quiet space on the third floor of the building, with wireless internet access, a shared kitchen, tables and shelves, can be used for work, events, workshops and exhibitions.
The Alt Lab consists of two areas – a common area and a laboratory. Laboratory equipment (laminar flow, PCR thermocycler, centrifuge, electrophoresis chamber, UV transilluminator, micropipettes, autoclave, incubator) is available upon instruction.
The lab is operated in collaboration with the Lithuanian Interdisciplinary Artists’ Association.
Headquarters office
Alt lab
Vitebsko 23, Studio 31
11350 Vilnius
Lithuania
Impressions
Photos: Andrej Vasilenko